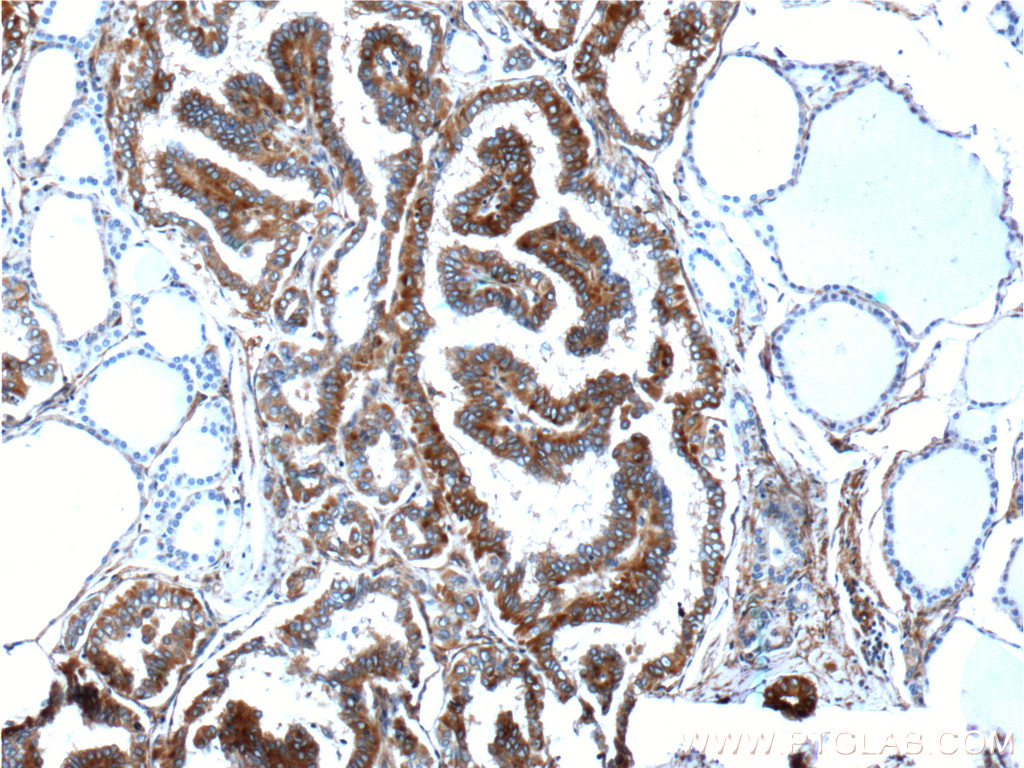

验证数据展示
经过测试的应用
| Positive WB detected in | HeLa cells, HEK-293 cells, Jurkat cells, NIH/3T3 cells, human peripheral blood platelets, rat kidney tissue |
| Positive IP detected in | NIH/3T3 cells |
| Positive IHC detected in | human thyroid cancer tissue, mouse brain tissue, mouse eye tissue Note: suggested antigen retrieval with TE buffer pH 9.0; (*) Alternatively, antigen retrieval may be performed with citrate buffer pH 6.0 |
| Positive IF-P detected in | rat eye tissue |
| Positive IF/ICC detected in | HeLa cells, NIH/3T3 cells, HepG2 cells |
| Positive FC (Intra) detected in | HeLa cells, Jurkat cells |
推荐稀释比
| 应用 | 推荐稀释比 |
|---|---|
| Western Blot (WB) | WB : 1:2000-1:12000 |
| Immunoprecipitation (IP) | IP : 0.5-4.0 ug for 1.0-3.0 mg of total protein lysate |
| Immunohistochemistry (IHC) | IHC : 1:20-1:200 |
| Immunofluorescence (IF)-P | IF-P : 1:50-1:500 |
| Immunofluorescence (IF)/ICC | IF/ICC : 1:50-1:500 |
| Flow Cytometry (FC) (INTRA) | FC (INTRA) : 0.40 ug per 10^6 cells in a 100 µl suspension |
| It is recommended that this reagent should be titrated in each testing system to obtain optimal results. | |
| Sample-dependent, Check data in validation data gallery. | |
产品信息
21991-1-AP targets PKC Alpha in WB, IHC, IF/ICC, IF-P, FC (Intra), IP, ELISA applications and shows reactivity with human, mouse, rat samples.
| 经测试应用 | WB, IHC, IF/ICC, IF-P, FC (Intra), IP, ELISA Application Description |
| 文献引用应用 | WB, IHC, IF, IP |
| 经测试反应性 | human, mouse, rat |
| 文献引用反应性 | human, mouse, rat, pig, monkey |
| 免疫原 |
CatNo: Ag17275 Product name: Recombinant human PRKCA protein Source: e coli.-derived, PGEX-4T Tag: GST Domain: 1-216 aa of BC109274 Sequence: MADVFPGNDSTASQDVANRFARKGALRQKNVHEVKDHKFIARFFKQPTFCSHCTDFIWGFGKQGFQCQVCCFVVHKRCHEFVTFSCPGADKGPDTDDPRSKHKFKIHTYGSPTFCDHCGSLLYGLIHQGMKCDTCDMNVHKQCVINVPSLCGMDHTEKRGRIYLKAEVADEKLHVTVRDAKNLIPMDPNGLSDPYVKLKLIPDPKNESKQKTKTIR 种属同源性预测 |
| 宿主/亚型 | Rabbit / IgG |
| 抗体类别 | Polyclonal |
| 产品类型 | Antibody |
| 全称 | protein kinase C, alpha |
| 别名 | PRKCA, AAG6, EC:2.7.11.13, PKC A, PKCA |
| 计算分子量 | 77 kDa |
| 观测分子量 | 77 kDa |
| GenBank蛋白编号 | AK055431 |
| 基因名称 | PKC Alpha |
| Gene ID (NCBI) | 5578 |
| RRID | AB_2878965 |
| 偶联类型 | Unconjugated |
| 形式 | Liquid |
| 纯化方式 | Antigen affinity purification |
| UNIPROT ID | P17252 |
| 储存缓冲液 | PBS with 0.02% sodium azide and 50% glycerol, pH 7.3. |
| 储存条件 | Store at -20°C. Stable for one year after shipment. Aliquoting is unnecessary for -20oC storage. |
背景介绍
Protein kinase C (PKC) is a family of serine- and threonine-specific protein kinases that can be activated by calcium and the second messenger diacylglycerol. PKC family members phosphorylate a wide variety of protein targets and are known to be involved in diverse cellular signaling pathways. PKC family members also serve as major receptors for phorbol esters, a class of tumor promoters. Each member of the PKC family has a specific expression profile and is believed to play a distinct role in cells. PRKCA is one of the PKC family members. This kinase has been reported to play roles in many different cellular processes, such as cell adhesion, cell transformation, cell cycle checkpoint, and cell volume control. Knockout studies in mice suggest that this kinase may be a fundamental regulator of cardiac contractility and Ca(2+) handling in myocytes.
实验方案
| Product Specific Protocols | |
|---|---|
| FC protocol for PKC Alpha antibody 21991-1-AP | Download protocol |
| IF protocol for PKC Alpha antibody 21991-1-AP | Download protocol |
| IHC protocol for PKC Alpha antibody 21991-1-AP | Download protocol |
| IP protocol for PKC Alpha antibody 21991-1-AP | Download protocol |
| WB protocol for PKC Alpha antibody 21991-1-AP | Download protocol |
| Standard Protocols | |
|---|---|
| Click here to view our Standard Protocols |
发表文章
| Species | Application | Title |
|---|---|---|
Adv Sci (Weinh) LncRNA Foxo6os as a Novel " Scaffold" Mediates MYBPC3 in Combating Pathological Cardiac Hypertrophy and Heart Failure | ||
Cancer Lett RSK2-mediated phosphorylation and degradation of UBE2O inhibits hepatocellular carcinoma growth and resistance to radiotherapy | ||
Theranostics MED13L integrates Mediator-regulated epigenetic control into lung cancer radiosensitivity. | ||
Cell Death Dis ATF4/CEMIP/PKCα promotes anoikis resistance by enhancing protective autophagy in prostate cancer cells. | ||
Cell Death Differ β-Trcp ubiquitin ligase and RSK2 kinase-mediated degradation of FOXN2 promotes tumorigenesis and radioresistance in lung cancer. | ||
Oncogene β-Trcp and CK1δ-mediated degradation of LZTS2 activates PI3K/AKT signaling to drive tumorigenesis and metastasis in hepatocellular carcinoma. |